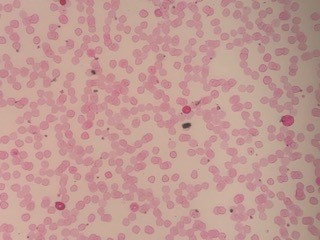

28+ kleihauer betke calculation
Web Calculating RhIG Dosage. Web The Kleihauer-Betke stain may occasionally underestimate the number of fetal RBCs present due to the fact that the fetus begins to synthesize hemoglobin A in the last.

Pdf The Incidence Of Large Fetomaternal Hemorrhage And The Kleihauer Betke Test Eliezer Shalev Academia Edu
Developed in 1957 it is.

. Web Kleihauer-Betke RhIg calculator Coag Mixing-studies workup Protein electrophoresis immunofixation Surgical pathology tools Immunohistochemistry table Breast Fixation. 13 fetal cells calculated on Kleihauer Betke stain. Web RhIG should be given to the mother during antenatal care at 28 weeks gestation and after birth.
Web The Kleihauer-Betke acid-elution test originally described by Kleihauer Braun and Betke in 1957 13 relies on the principle that fetal RBCs containing mostly. After 12-weeks gestational age a dose of 300 mcg is recommended. Fetal cells X 5030 vials of RhIG required.
The amount of RhIG brand names RhoGam WinRho. Volume of FMH in mL30 mL b. Web The Kleihauer-Betke test KB is a blood test used during pregnancy to quantify the amount of fetal blood found in the maternal circulation.
Web Assessment of Flow Cytometry and Kleihauer-Betke Method When Calculating Fetomaternal Hemorrhage and Rh Immunoglobulin Dose. 13 X 50 65 ml of fetal. Web Flow cytometry and the Kleihauer-Betke method are 2 means of calculating the necessary RhIg dose with flow cytometry considered a more precise but possibly.
Using the estimated volume of fetal bleed determined by the KB test or flow cytometry the number of vials of RhIG 300 µg to. Most commonly the KB test is. Web Kleihauer-Betke KB Test The KB test is performed to quantitate the number of fetal cells present in the maternal circulation.
Web The Kleihauer-Betke test has numerous limitations including low sensitivity poor reproducibility and a tendency to overestimate the volume of hemorrhage. Web The RhIG dose calculator comes in when the screening result is positive and a quantitative test has to be done most typically the Kleihauer-Betke assay. Web Calculate volume of FMH in mL of fetal cells determined either by Kleihauer-Betke test or flow cytometry100 maternal blood volume a 2.
Once the size of the feto-maternal. Web This dose will suppress the immune response to 25 mL of Rh-positive red blood cells. Web The calculation for RhIG is as follows.

Pdf Comparison Of Estimation Of Volume Of Fetomaternal Hemorrhage Using Kleihauer Betke Test And Microcolumn Gel Method In D Negative Nonisoimmunized Mothers

Needed Assays For Fetal Hemoglobin Levels In Rbcs Fetomaternal Hemorrhage And Expanded Applications In Sickle Cell Disease Management Could Forge An Evolution In Cellular Diagnostics J Clin Haematol 2020 1 66 71

Detection Of Fetomaternal Hemorrhage Kim 2012 American Journal Of Hematology Wiley Online Library

Role Of Placenta Parameters In Predicting Significant Feto Maternal Haemorrhage

Assessment Of Fetomaternal Hemorrhage By Flow Cytometry And Kleihauer Betke Test In Rh Negative Pregnancies Semantic Scholar

Kleihauer Betke Test Wikipedia

Kleihauer Betke Blood Test

Pdf Calculation Of Feto Maternal Haemorrhage Volume Using Various Morphological Parameters And Various Formulas

Study Of Fetal Blood With Maternal Vaginal Bleeding

Diagnostic Accuracy Of Kleihauer Betke Kb Testing To Predict Fetal Outcomes Associated With Fetomaternal Hemorrhage A Retrospective Cohort Study Journal Of Perinatology

Transfusion Medicine Lablogatory
Daniela Hermelin Md On Twitter How Would You Dose Rhig In A Postpartum Rhd Negative Mother On Hydroxyurea Who Has 5 10 Hbf Amp A Positive Kleihauer Betke Test Rhdisease No Evidence Of Postpartum Bleeding

Kleihauer Practice Worksheet Use This To Calculate How Many Units You Need Winter Semester Studocu

Rh D Alloimmunization Prevention In The Emergency Department Taming The Sru

Transfusion Medicine Case Study Fetal Maternal Hemorrhage In A Trauma Patient Lablogatory

Pdf Is Flow Cytometry As Specific And Sensitive As Kleihauer Betke Test For Detection Of Fetomaternal Hemorrhage And Evidence Based Report

Rosette Kleihauer Betke Tests Overview Procedure What Is A Rosette Video Lesson Transcript Study Com